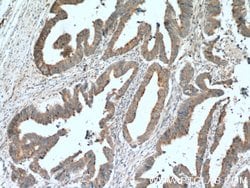
LIPA Rabbit anti-Human, Mouse, Rat, Polyclonal, Proteintech 150 &mu;L;

missing translation for 'onlineSavingsMsg'
Learn More
Learn More
LIPA Rabbit anti-Human, Mouse, Rat, Polyclonal, Proteintech
Rabbit Polyclonal Antibody
Brand: Proteintech 12956-1-AP-150UL
This item is not returnable.
View return policy
Description
This gene encodes lipase A, the lysosomal acid lipase (also known as cholesterol ester hydrolase). This enzyme functions in the lysosome to catalyze the hydrolysis of cholesteryl esters and triglycerides. Mutations in this gene can result in Wolman disease and cholesteryl ester storage disease. Alternatively spliced transcript variants encoding the same protein have been found for this gene.Specifications
| LIPA | |
| Polyclonal | |
| Unconjugated | |
| LIPA | |
| CESD, Cholesteryl esterase, LAL, LIPA, Lipase A, Sterol esterase | |
| Rabbit | |
| Antigen Affinity Chromatography | |
| RUO | |
| 16889, 25055, 3988 | |
| -20°C | |
| Liquid |
| Immunohistochemistry (Paraffin), Western Blot | |
| 0.21 mg/mL | |
| PBS with 50% glycerol and 0.1% sodium azide; pH 7.3 | |
| P38571, Q64194, Q9Z0M5 | |
| LIPA | |
| LIPA Fusion Protein Ag3627 | |
| 150 μL | |
| Primary | |
| Human, Mouse, Rat | |
| Antibody | |
| IgG |
Product Content Correction
Your input is important to us. Please complete this form to provide feedback related to the content on this product.
Product Title
Spot an opportunity for improvement?Share a Content Correction